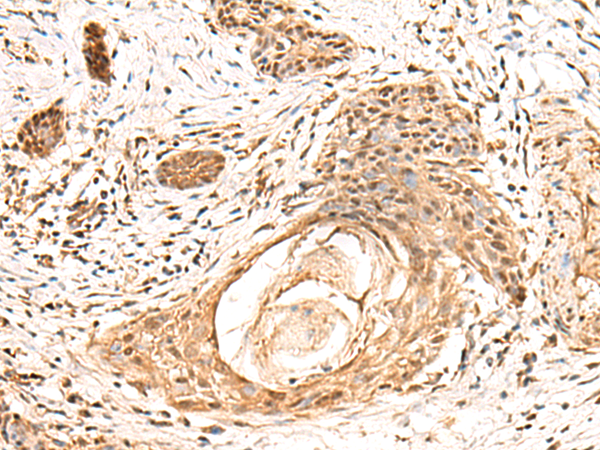

技術規格
|
Background: |
Substrate-specific adapter of a BCR (BTB-CUL3-RBX1) E3 ubiquitin-protein ligase complex involved in regulation of cytoskeleton structure. The BCR(BACURD1) E3 ubiquitin ligase complex mediates the ubiquitination of RHOA, leading to its degradation by the proteasome, thereby regulating the actin cytoskeleton and cell migration. |
|
Applications: |
ELISA, IHC |
|
Name of antibody: |
KCTD13 |
|
Immunogen: |
Fusion protein of human KCTD13 |
|
Full name: |
potassium channel tetramerization domain containing 13 |
|
Synonyms: |
PDIP1; FKSG86; BACURD1; POLDIP1; hBACURD1 |
|
SwissProt: |
Q8WZ19 |
|
ELISA Recommended dilution: |
5000-10000 |
|
IHC positive control: |
Human esophagus cancer |
|
IHC Recommend dilution: |
50-300 |
購物車
購物車 幫助
幫助
 021-54845833/15800441009
021-54845833/15800441009
